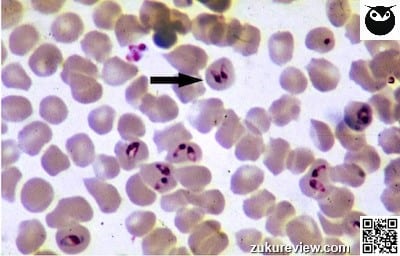
eqbldsm16.20small 125

Expect fever, petechiations, and hemolytic anemia with acute piroplasmosis. This cytology shows Babesia caballi, one of the causative agents of equine piroplasmosis (the other is Theileria equi – looks like a maltese cross under the microscope).
Piroplasmosis is characterized by hemolytic anemia and is spread primarily by ixodid ticks or blood contamination. It is endemic in tropical, subtropical, and some temperate regions. Clinical infection can be acute, chronic, or inapparent, depending on strain, the horse’s health, and geographic region.
It is REPORTABLE in the USA.
Acute clinical signs include those described here along with lethargy, anorexia, pale or icteric mucous membranes, and with worsening disease – tachycardia, tachypnea, weakness, and hemoglobinuria. Weight loss, poor performance, and partial anorexia can be seen along with mild anemia in horses with chronic piroplasmosis.
Dx: Demonstrate intra-erythrocytic organisms on blood smear and/or serology.
Tx: Imidocarb dipropionate and supportive care. There is a different duration of Tx depending on whether in endemic or nonendemic region (because trying to treat clinical signs in endemic region vs. clear disease in nonendemic region).
Limb edema, ventricular arrhythmias, and ataxia (the latter two uncommonly) can be seen with Anaplasma phagocytophila infections in horses, along with fever, petechiations, icterus, and depression.
Image courtesy of Alan R. Walker.